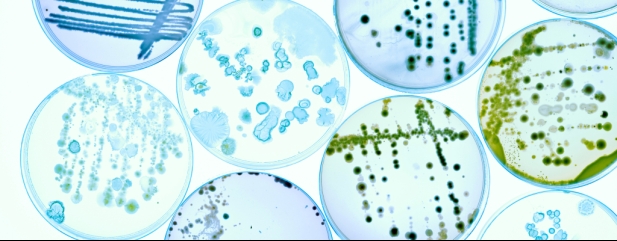

Since inception in October 2019 RTW Biotech Opportunities (RTW) has delivered 65.3% growth in NAV (net asset value), smashing the performance of the Russell 2000 Biotech index which is down 0.7% as well as the NBI (Nasdaq Biotech Index) which is up 20.6% over the same period.

Despite the superior performance to the benchmark and peers, the shares trade at an unwarranted 23% discount to NAV, representing a great chance to buy.
The NBI has endured the second largest ever correction in its history losing 70% from the post-pandemic peak which has created a big opportunity for specialist managers to exploit.
RTW is well placed to take advantage of the gloom and value in the biotech space having received (16 June) proceeds of $99.1 million related to Merck’s (MRK:NYSE) takeover of portfolio company Prometheus Biosciences. This represented a return of 11.8 times on its initial investment.
Part of the reason for the shares trading at a discount is that the name of the trust until 27 June was RTW Venture Fund suggesting it was a riskier biotech venture capital investor, which it is not.
Secondly, the sector is deeply out of favour as seen by the huge correction in the NBI in the last two years and funds often trade at a discount when sentiment is poor.
The name change should mean prospective investors START comparing the trust to well-known peers Bellevue Healthcare Trust (BBH), International Biotechnology Trust (IBT) and Worldwide Healthcare Trust (WWH).
RTW is a full life cycle investor which means it can invest in different stages of a company’s development and has the flexibility to focus on the most attractive parts of the market. It is looking to identify next-generation therapies which can significantly improve patients lives. The investment in Prometheus, which is focused on treatments for diseases caused by abnormal activity of the body’s immune system, is a good example of the manager’s approach.
It co-led a private placing round in 2020 which raised $130 million then participated in the initial public offering in March 2021 and a further $500 million fundraise in December 2022.
The proceeds from the Prometheus exit will be used partly to address the discount to NAV where the company intends to conduct an ‘NAV-accretive’ share buyback of up to $10 million.
Given the attractive valuations on offer in biotech and increasing mergers and acquisitions, the board believes an ‘appropriate level’ of the proceeds should be invested into ‘highly attractive’ opportunities.
‹ Previous2023-07-13Next ›
magazine
magazine









